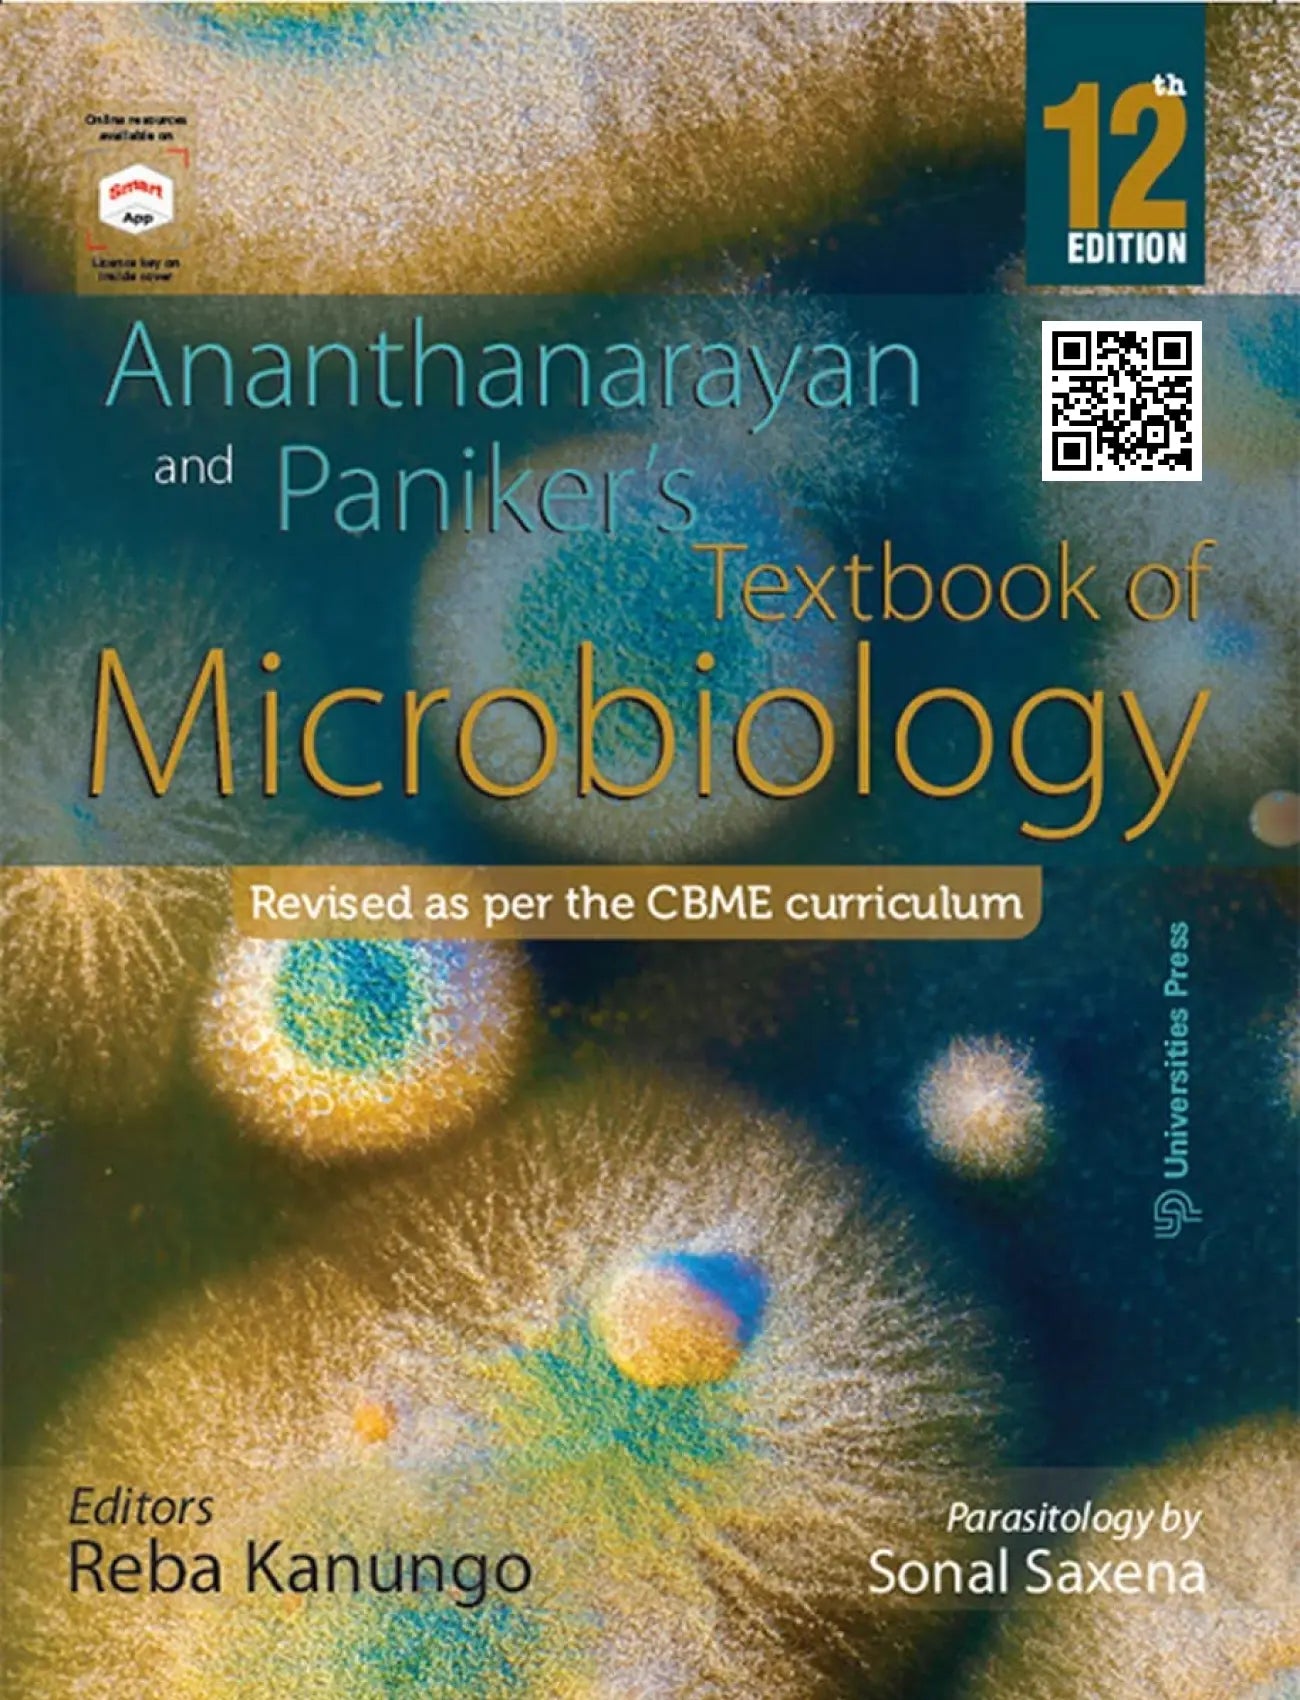

1
/
of
1
Ananthanarayan And Paniker's Textbook Of Microbiology 12th Edition
Ananthanarayan And Paniker's Textbook Of Microbiology 12th Edition
Regular price
Rs. 1,100.00
Regular price
Rs. 1,250.00
Sale price
Rs. 1,100.00
Shipping calculated at checkout.
Quantity
Couldn't load pickup availability
Product details
Publisher : Universities Press (India) Pvt. Ltd
Author : R Ananthanarayan , CK Jayaram Paniker
Language : English
Edition : 12th Edition
ISBN-10 : 9393330018
ISBN-13 : 9789393330017
Ananthanarayan and Paniker’s Textbook of Microbiology is an essential reference guide for students of Microbiology and Biosciences. It covers all aspects of the discipline in-depth and is written by R Ananthanarayan and CK Jayaram Paniker, two experts in their field. It is an exhaustive textbook that provides the latest scientific developments in the field.
Materials
Materials
Paper
Shipping & Refunds
Shipping & Refunds
Share
1
/
of
4